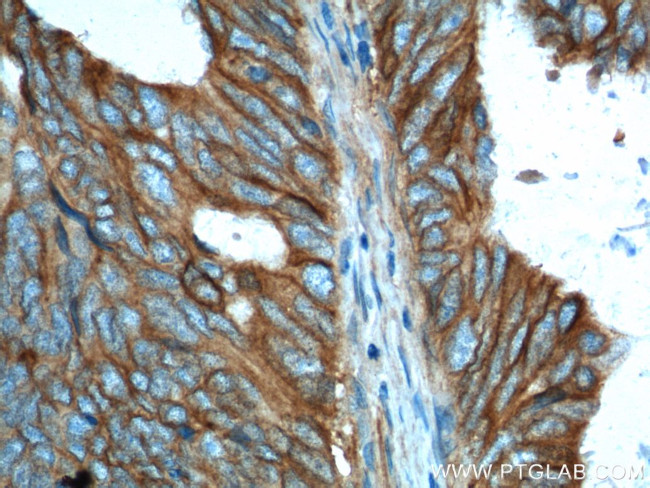
PTK7 Antibody in Immunohistochemistry (Paraffin) (IHC (P))

Search
Proteintech
PTK7 Polyclonal Antibody
{{$productOrderCtrl.translations['antibody.pdp.commerceCard.promotion.promotions']}}
{{$productOrderCtrl.translations['antibody.pdp.commerceCard.promotion.viewpromo']}}
{{$productOrderCtrl.translations['antibody.pdp.commerceCard.promotion.promocode']}}: {{promo.promoCode}} {{promo.promoTitle}} {{promo.promoDescription}}. {{$productOrderCtrl.translations['antibody.pdp.commerceCard.promotion.learnmore']}}
产品信息
17799-1-AP
种属反应
已发表种属
宿主/亚型
分类
类型
抗原
偶联物
形式
浓度
规格
纯化类型
保存液
内含物
保存条件
运输条件
产品详细信息
Immunogen sequence: FYCKKRCKA KRLQKQPEGE EPEMECLNGG PLQNGQPSAE IQEEVALTSL GSGPAATNKR HSTSDKMHFP RSSLQPITTL GKSEFGEVFL AKAQGLEEGV AETLVLVKSL QSKDEQQQLD FRRELEMFGK LNHANVVRLL GLCREAEPHY MVLEYVDLGD LKQFLRISKS KDEKLKSQPL STKQKVALCT QVALGMEHLS NNRFVHKDLA ARNCLVSAQR QVKVSALGLS KDVYNSEYYH FRQAWVPLRW MSPEAILEGD FSTKSDVWAF GVLMWEVFTH GEMPHGGQAD DEVLADLQAG KARLPQPEGC PSKLYRLMQR CWALSPKDRP SFSEIASALG DSTVDSKP (724-1070 aa encoded by BC071557)
靶标信息
CCK4 may function as a cell adhesion molecule. Although it belongs to the insulin receptor subfamily of the Tyr protein kinases, it likely lacks the catalytic activity of a tyrosine kinase. It may be connected to the pathophysiology of colon carcinomas and/or may represent a tumor progression marker. This Type I membrane protein is highly expressed in lung, liver, pancreas, kidney, placenta and melanocytes, but weakly expressed in thyroid gland, ovary, brain, heart and skeletal muscle, and not in colon. It is also expressed in erythroleukemia cells.
仅用于科研。不用于诊断过程。未经明确授权不得转售。
生物信息学
蛋白别名: CCK-4; Colon carcinoma kinase 4; Inactive tyrosine-protein kinase 7; Protein chuzhoi; Protein-tyrosine kinase 7; Pseudo tyrosine kinase receptor 7; PTK7 protein tyrosine kinase 7; receptor protein tyrosine kinase-like molecule; receptor tyrosine kinase-like protein; serum response factor; splice variant 1; splice variant 2; splice variant 3; splice variant 4; splice variant 5; Tyrosine-protein kinase-like 7; unnamed protein product
基因别名: 8430404F20Rik; CCK-4; CCK4; chz; mPTK7/CCK4; PTK7; Srf
UniProt ID: (Human) Q13308, (Mouse) Q8BKG3
Entrez Gene ID: (Human) 5754, (Rat) 301242, (Mouse) 71461